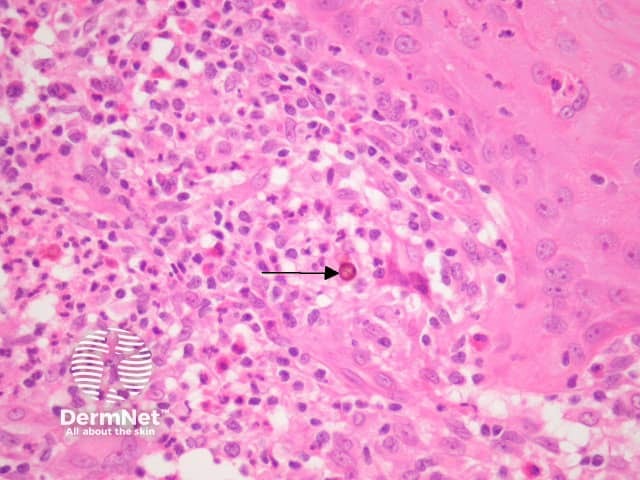
Figure 6

Main menu
Common skin conditions
NEWS
Join DermNet PRO
Read more
Quick links
Infections Diagnosis and testing
Author: Assoc Prof Patrick Emanuel, Dermatopathologist, Auckland, New Zealand, 2013.
Chromoblastomycosis (chromomycosis) is caused by quite a variety of pigmented fungal species common in soil and plant matter.
Chromoblastomycosis organisms often elicit a profound epidermal hyperplastic reaction which may mimic a squamous cell carcinoma (figures 1, 2). There are often intraepidermal neutrophilic abscesses and transepidermal elimination of inflammatory debris. There is a suppurative and granulomatous response in the dermis (figure 3-6). Eosinophils may be numerous. Later stages often show an impressive dermal fibroplasia.
Within the infiltrate, the organisms can be seen on haematoxylin-eosin sections (figures 3-6, arrows). The organisms are brown, round and have a thick wall. They are thought to represent an intermediate form between hyphae and yeast. The round bodies are sometimes seen fused together as “septate bodies” (figure 4, arrows).

Figure 1

Figure 2

Figure 3

Figure 4

Figure 5
Figure 6
GMS and PAS stains can highlight the fungal forms. The pigment can be appreciated on haematoxylin-eosin sections. Fungal culture can be used to isolate the causative organism.
Phaeohyphomycosis – Pigmented hyphae are the hallmark of phaeohyphomycosis rather than the round intermediate bodies of chromoblastomycosis.
Sporotrichosis, blastomycosis, coccidiodomycosis, mycobacterial infection – Special stains, culture or PCR can be helpful in difficult cases.
Squamous cell carcinoma, halogenoderma – The massive epidermal hyperplasia which often accompanies chromoblastomycosis my cause diagnostic confusion with these other diverse pathologic processes.